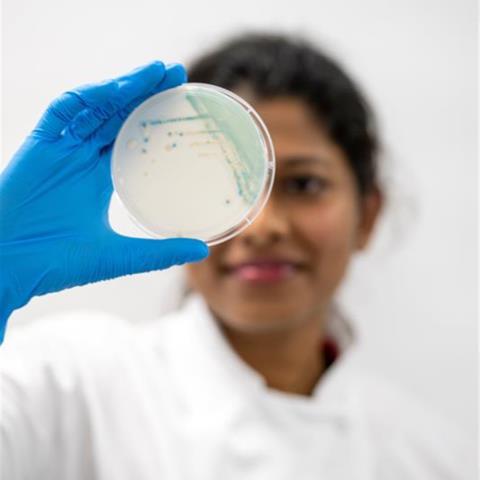
Lab-A07

Chris Armstrong, President of Microbiology with Thermo Fisher Scientific, argues that laboratories should stop judging fungal culture media on unit price alone. In an era of staffing shortages, rising complexity and the spread of increasingly aggressive pathogens, chromogenic media should be assessed on total workflow value, not the price of the plate.

For years, many laboratories have treated culture media as a commodity purchase, deciding which plate to purchase based on unit price. The thinking is familiar: if the plate is cheaper, the lab is saving money. I would argue that this logic no longer stands up to the reality of modern microbiology in the face of emerging health threats.
A plate is not a cost in isolation; it is the starting point of a workflow. In 2026, the real pressure on that workflow is not just budgets, it is labor, consistency and speed.
An American Society for Microbiology’s workforce survey found that 80% of responding clinical microbiology laboratories had open positions for medical laboratory scientists. When skilled people are scarce, every extra read, every extra subculture and every unnecessary confirmation step becomes more expensive than procurement teams often realize.
The argument becomes stronger still when we talk about Candida auris (Candidozyma auris). The World Health Organization classifies C. auris as a critical priority fungal pathogen and has called for stronger laboratory capacity and surveillance. The U.S. Centers for Disease Control and Prevention (CDC) say C. auris can cause severe multidrug-resistant illness in hospitalized patients, and reported 6,304 U.S. clinical cases in 2024, with cases continuing to rise each year.
In Europe, the European Centre for Disease Prevention and Control (ECDC) warned in 2025 that C. auris is rapidly spreading across healthcare systems and that preparedness gaps remain. Run-away C. auris spread poses additional stress on an already over-burdened clinical landscape that has to tackle rising antimicrobial resistance across the board. Reports have identified echinocandin-resistant C. auris within the Greek healthcare system.
Tactical response
That is why I believe laboratories should consider evaluating next generation chromogenic media within their Candida workflows, even if the plate price is higher than traditional media. This is not a modern upgrade; it is a practical response to the economics of running a pressured laboratory and a tactical response in light of the strongly evidenced threat posed by C. auris.
Traditional media may appear less expensive on unit price, but some laboratories may find that interpretation time, repeat work, additional confirmation steps and staffing demands affect overall workflow cost.
This matters because the skills shortage is not only about headcount. It is also about experience. Labs everywhere are asking newer colleagues to do more, more quickly, with less time for hands-on training. A method that is easier to interpret, easier to standardize and easier to fit into existing automation is not simply a “nice to have”; it is a way of protecting quality while reducing dependence on scarce specialist judgement. The right chromogenic medium can help make good microbiology more repeatable across shifts, sites and staffing levels.
Other Candida threats
Aside from the detection of C. auris, timely and adequate detection of other Candida species remains relevant too – resistance to azoles, a class of medicines used to treat fungal infections, in Candida parapsilosis complicates matters even more.
This data changes the debate. When a pathogen carries infection prevention consequences as well as clinical ones, delays and ambiguity become more costly. Where identification is relevant to infection-prevention workflows, delays in obtaining clear presumptive results may affect the timing of downstream laboratory and institutional decision-making.
For that reason, I believe labs should stop treating chromogenic media as a premium niche option for C. auris and start seeing it as part of sensible front-line preparedness.
The case for culture
That said, culture should not be oversimplified. The CDC notes that MALDI-TOF mass spectrometry is the most reliable method for identifying C. auris, and that real-time PCR is the preferred method for detecting colonization.
While this may be true, it does not weaken the case for chromogenic media. In the real world, laboratories need practical front-end tools that support screening, triage and efficient workflow before, alongside or after confirmatory methods.
Well-designed chromogenic media can support C. auris screening workflows under defined incubation conditions while also improving detection of mixed Candida populations and supporting downstream susceptibility testing.
Performance characteristics
Additionally, performance characteristics may vary across chromogenic media. Published studies show that colony morphology on certain chromogenic formulations may overlap with C. auris, meaning additional confirmatory work may be needed and confidence can fall away just when clarity matters most.
That is why the real question is not whether labs should use chromogenic media, but whether they are using chromogenic media to support timely presumptive screening within validated workflows. The answer should be guided by performance, workflow fit and clinical relevance.
So, while chromogenic media may cost more per plate, that should not be the determining factor. The total workflow cost should be what drives the decision: staff time, repeat testing, storage burden, delayed reporting, inconsistent interpretation and missed opportunities to act sooner.
In a time when labor shortages continue to rise and more and more fungal threats emerge, a lower plate price does not always translate into lower overall workflow cost. Depending on workflow design and staffing constraints, some laboratories may find that chromogenic media supports a more efficient overall cost profile.









No comments yet